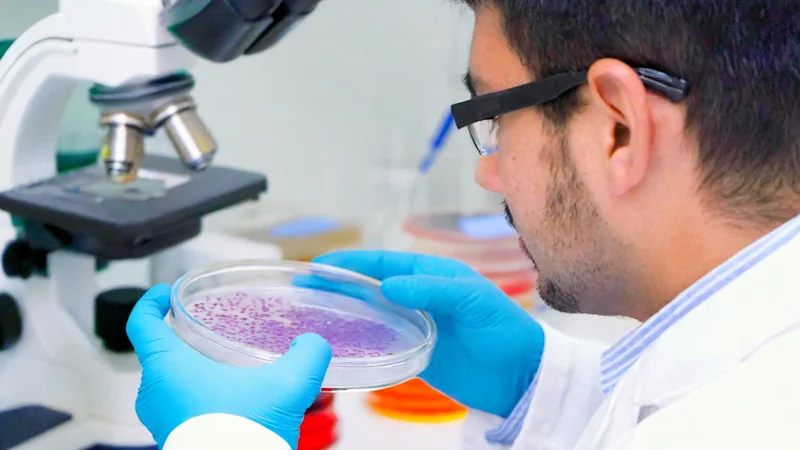
Scientist doing culture work

Stricter Biocide Regulations Needed to Protect Dutch Water Quality, Say Water Authorities
Dutch water authorities call for stronger biocide regulation to protect water quality and meet EU Water Framework Directive goals.

The European Commission has issued Implementing Regulation (EU) 2023/2747, effectively amending the Union authorisation for the biocidal product family, 'Lactic acid based products – CID Lines NV'. This amendment, dated 8 December 2023, follows Regulation (EU) No 528/2012 of the European Parliament and of the Council.
Originally, on 26 July 2022, the European Union granted authorisation to CID Lines NV for the market release of their 'Lactic acid-based products'. This approval was contingent on the company conducting long-term storage stability tests and reporting the results to the European Chemicals Agency (ECHA) by 1 March 2023.
A key consequence of this amendment is the removal of the 'Wipe 4 2L (105 wipes)' packaging from the Union authorisation. This decision aligns with the findings that this specific packaging type does not meet the required shelf life criteria. The entire Annex II to Implementing Regulation (EU) 2022/1391 has been replaced to reflect this update.
The 'Lactic acid based products – CID Lines NV' encompasses various disinfectant products suitable for human hygiene, veterinary hygiene, and use in the food and feed area.
One of the products under this family, 'Kenosan Hand Scrub', is specifically designated for the EU market.
Stakeholders and users of 'Lactic acid based products – CID Lines NV' should update their practices according to this amendment. It's crucial to adhere to the safety and usage guidelines provided, ensuring compliance with the latest regulatory standards.
Foresight continuously tracks 1000s of sources and maps updates to your portfolio:




Dutch water authorities call for stronger biocide regulation to protect water quality and meet EU Water Framework Directive goals.

EFSA launches consultation on updating its Weight of Evidence and Biological Relevance guidance, aiming to streamline chemical risk assessment practices.

At the 109th CA meeting, EU authorities prioritised new guidance, addressed microplastics restrictions, and warned of delays in the biocides review programme.
Subscribe to Foresight Weekly and get the latest insights on regulatory changes affecting chemical compliance.
Free forever. Unsubscribe anytime.
Read by professionals at